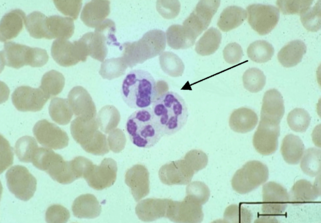

VDV-1467 (677545)
Текст из файла
Аннотация
Создана и реализована, в виде компьютерной программы, математическая модель движения популяции клеток. Показано, что широко принятое в литературе деление нейтрофилов на медленные, средние и быстрые следует считать условным. Экспериментальные измерения скоростей нейтрофилов в популяции распределены непрерывно. Модель подвергает сомнению широко принятое мнение о существовании памяти нейтрофилов. Экспериментальные данные хорошо описываются в рамках марковской модели. Наблюдаемое в эксперименте закономерное возвращение некоторых нейтрофилов к начальной точке связано только с недостатком статистики для измерения среднеквадратичного отклонения на больших временах.
Содержание
Аннотация 1
Введение 3
Физиология нейтрофилов 5
Общая характеристика 5
Рецепторы в плазматической мембране 8
Механизмы активации нейтрофилов 9
Подвижность нейтрофилов 13
Методы исследования подвижности нейтрофилов 17
Алгоритм работы модели клетки 22
Вычисление координат клетки 24
Генерация случайных чисел с заданным распределением (Монте-Карло) 25
Программная реализация алгоритма 28
Процедура редактирования распределений 31
Измерение среднеквадратичного отклонения 33
Результаты исследования 34
Измерение пройденного пути 36
Исследование зависимости среднеквадратичного отклонения от времени наблюдения 43
Заключение 49
Выводы 52
Список литературы 53
Приложение 55
Текст программы математического моделирования случайного блуждания популяции нейтровилов 55
Введение
В настоящее время подвижность нейтрофилов рассматривается, как очень важный показатель физиологического состояния лейкоцитов в борьбе с инфекцией. С нарушением подвижности нейтрофилов связывают многие заболевания. Поэтому изучение механизма движения представляет актуальную задачу современной медицины. На сегодняшний день накоплен достаточно большой материал, который позволяет выстраивать гипотезу относительно движения нейтрофилов. Однако эти гипотезы трудно проверить экспериментально потому, что эти методы основаны на покадровой съемке с фиксированным временным интервалом. Простое визуальное наблюдение не позволяет накопить достоверный материал, поэтому приходится прибегать к математическому моделированию.
Модель показывает, какое большое значение в оценки двигательной активности нейтрофила имеет выбор величины межкадрового интервала.
В наших экспериментах, для оценки внешнего движения (перемещение сравнимое с диаметром клетки) был выбран одноминутный межкадровый интервал, а для оценки движения, связанного с изменениями площади клетки, был выбран двухсекундный интервал.
Задачей дипломной работы было создание математической модели движения популяции клеток. Эта модель должна имитировать процесс движения клеток, процесс измерений основных характеристик движения. А полученные на модели результаты должны сравниваться с соответствующими экспериментальными данными, полученные в институте хирургии им А. В. Вишневского.
Физиология нейтрофилов
Общая характеристика
Нейтрофилы – одни из типов белых кровяных клеток – лейкоцитов.
рис. 1 Нейтрофилы
Нейтрофилы многочисленные и очень подвижные клетки. При появлении бактерий нейтрофилы начинают активный выход в ткани, где движутся в очаг воспаления с помощью различных реакций инактивируют (поглощают и разрушают бактерии).
Нейтрофилы – проявляют следующие функции:
-
Способность к адгезии (прилипание) и изменение формы.
-
Способность к движению
а) случайное блуждание;
б) хемотаксис (направленное движение отдельных клеток под влиянием односторонне действующего стимула – химического вещества)
в) хемокинез (реакция на внешний стимул, выражающиеся в изменении скорости, частоты, смены периодов движения или частоты и амплитуды поворотов во время случайного блуждания.)
-
Способность к распознаванию чужеродных агентов.
Нейтрофил с помощью рецепторов распознает бактерии.
-
Способность к фагоцитозу.
Фагоцитоз – активный захват и поглощение частиц – нейтрофилами. Фагоцитоз – одна из защитных реакций организма, главным образом при воспалении, открыт в 1883 г. И. И. Мечниковым.
-
Микробицидная активность.
Продукция кислородных радикалов и секреция ферментов, содержащихся в гранулах.
Нарушение любой из этих функций нейтрофила приводит к осложнению воспалительной реакции. (Quie P.G. Mills E.L., McPhail L.C. Johnston R.B. 1987)
Нейтрофилы созревают в костном мозге в течении 6-11 дней, после чего выходят в кровяное русло, где передвигаются током крови и дозревают около 10 часов. Зрелые нейтрофилы выходят в ткань, где движутся от 24 до 48 часов.
При инфекции кинетика этих процессов ускоряется (RepoH 1987).
Различают 3 состояния существования нейтрофилов:
-
Клетки костномозгового резерва. Такие клетки отличаются меньшей адгезивностью и хемолюминисценцией на действие активатора.
-
Клетки пассивно циркулирующие в кровяном русле.
-
Клетки прикрепленные к слою клеток, выстилающих внутреннюю поверхность кровяных и лимфатических сосудов. Выход нейтрофилов в ткань происходит через 2-4 часа после появления инфекции.
Существует 3 этапа выхода нейтрофилов в ткань:
-
Краевое стояние лейкоцитов у внутренней поверхности эндотелия сосудов воспаленной ткани.
-
Диапедез – прохождение лейкоцитов через стенку эндотелия (длится несколько минут).
-
Движение нейтрофилов в области воспаления.
Выйдя в ткань, нейтрофил начинает активное движение в области воспаления.
Рецепторы в плазматической мембране
В покоящемся состоянии нейтрофилы очень слабо проявляют свои возможности, но они могут быть активированы через мембранные рецепторы. Имеются рецепторы на определенные вещества которые выделяются в тканях в процессе воспаления. Специфические рецепторы на мембране идентифицированы для C5a белкового фрагмента комплемента, N – формил - пептида, липидного хемоаттрактанта лейкотриена B4 (Snyderman R, Goetzl E.J. 1981). Фрагмент комплемента C5a образуется в плазме крови при активации комплимента. N – формил-пептид является продуктом бактерий, и митохондрий поврежденных тканей. LTB4 - Липидный медиатор, высвобождаемый при активации различных клеток, в том числе и самих нейтрофилов. К распознаванию чужеродных для организма частиц и поглощение их есть мембранные рецепторы к C3b и C3bi факторам комплемента. При адгезии нейтрофилов к эндотелию сосудов, есть рецепторы адгезии – интегрины и селектины (Springer T.A. 1990). Взаимодействие интегринов с адгезивными белками, содержащими специфическую аминокислотную последовательность Arg – Gly – Asp (RGP – последовательность) влияет на адгезивность клеток, и участвуют в активации нейтрофилов. RGP последовательность угнетает респираторный взрыв нейтрофилов на формил – пептид и, возможно, защищает их от спонтанной активации в кровяном русле.
Механизмы активации нейтрофилов
Под активацией нейтрофилов подразумеваются быстро наступающие изменения физиологической и биохимической активности при действии внешнего сигнала. Критерием активированного состояния принято считать появление респираторного взрыва и секреторной дегрануляции (Маянский А. Н., Маянский Д. Н. 1989).
Наиболее характерным ответом нейтрофилов на присоединение агонистов к рецепторам является накопление в нейтрофилах перекиси водорода для того, чтобы убить бактерии нейтрофил нарабатывает активные радикалы кислорода, уничтожая при этом не только бактерии, но и другие клетки организма – хозяина. Респираторный взрыв подчиняется сильному контролю из – за того, что его продукты высоко реактивны и токсичны. Такой «взрыв» направлен и против организма - хозяина и приводит к повреждениям тканей. При сильных повреждениях тканей у больных, когда есть возможность хирургического вмешательства, антибактериальной терапии, врачи избегают естественного течения воспалительного процесса и применяют противовоспалительную терапию.
В зрелых нейтрофилах существует два основных типа гранул: азурофильные и специфические. При воздействии на нейтрофилы растворимыми агонистами происходит дегрануляция нейтрофилов. Часть гранул, расположенных в близи плазматической мембраны сливается с мембраной и содержимое гранул высвобождается во внеклеточную среду. С наружной клеточной мембраной сливаются сначала специфические гранулы и уже затем – азурофильные. Такой тип дегрануляции характерен для «несостоявшегося фагоцитоза». При состоявшемся фагоцитозе бактерия захватывается мембраной нейтрофила со всех сторон, попадает в цитоплазму, где происходит её разрушение.
В нейтрофилах обнаружены универсальные механизмы передачи сигналов через G- белки, систему вторичных мессенджеров и фосфорилирование с участием протеинкиназ. G – белки представляют семейство гомологичных белков, плазматической мембраны, которые переносят информацию с рецепторов на ряд мембранных ферментов. Через G – белки действуют все агонисты, регулирующие активность аденилатциклаза, фосфолипазы А2, калиевых каналов. Фермент аденилатциклазы является интегральным белком плазматической мембраны, этот фермент отвечает за синтез сАМР в клетке. Одним из ранних событий после взаимодействия хемоаттрактантов с рецепторами является гидролиз мембранных фосфолипидов и образование биологически активных липидов. В процессе активации нейтрофилов участвуют три типа фосфолипаз: Фосфолипаза А2(PLA2), фосфолипаза С(PLC), фосфолипаза D(PLD) (Thelen et al. 1993).
Активация фосфолипазы С хемоаттрактантами осуществляется через G – белки. Фосфолипаза С расщепляет фосфолипид с образованием двух вторичных мессенжиров. Инозитолтрисфосфата (IP3) и диацилглицерина (DAG). Инозитолтрисфосфат связывается с рецепторами на внутриклеточных запасниках кальция, локализованных вблизи плазматической мембраны. Связывание IP3 с рецепторами индуцирует высвобождение, Са++ из запасников и увеличение концентрации свободного Са++ в цитоплазме. Другой вторичный мессенжер диацилглицерин остается ассоциированным с плазматической мембраной и активирует протеинкиназу С (Omann et al. 1987, Thelen et al. 1993).
Механизм активации фосфолипазы А2 неизвестен.
Фосфолипаза D нейтрофилов Са++ зависима, она гидролизует фосфатидилхолин с образованием потенциального вторичного мессенжира – фосфатидной кислоты. Фосфатидная кислота расщипляется с образованием диацилглицерина – физиологического активатора протеинкиназы С. Процессы протекающие на плазматической мембране при взаимодействии легандов с рецепторами приводит к образованию в клетке низкомолекулярных продуктов циклических нуклеотидов, диацилглицерин, ионы кальция.
Циклические нуклеотиды не являются активаторами нейтрофилов, хотя кратковременное увеличение сАМР в нейтрофилах наблюдается при различных рецепторных активациях. Увеличение содержания сАМР угнетает двигательную активность нейтрофилов. (Галкин А.А. и соавт. 1994)
сАМР не блокирует быстрого увеличения внутриклеточного Са++ при активации нейтрофилов хемоаттрактантами. (Takenawa T., Ishitoya J., Nagai Y. 1986).
Дибутирильный сGMP сам по себе не вызывает активацию нейтрофилов и модулирует активацию нейтрофилов вызванную различными хемоаттрактантами сGMP в концентрациях в отличие от сАМР, значительно усиливает миграцию нейтрофилов (Галкин А.А. и соавт. 1994).
Ионы кальция основной частью находится в связанном состоянии и заключаются в ядре и митохондриях. При стимуляции нейтрофилов хемоаттрактантами происходит Са – зависимое кратковременное преходящее увеличение внутриклеточной концентрации Са++, которое обеспечивается из 2х источников; быстрого высвобождения Са++ из обмениваемого внутриклеточного источника и поступления Са++ извне. Извне Са++ поступает через плазматическую мембрану, проходит через рецепторуправляемые кальциевые каналы. Поддержание равновесия концентрации Са в клетке обеспечивается с одной стороны выведением Са++ из цитоплазмы кальциевыми насосами, с другой поступлением Са++ из окружающего раствора. Участие Са++ в регуляции активности нейтрофилов не ясно. Можно сказать, что подвижность нейтрофилов либо не связана с изменениями, либо связана с небольшими локальными изменениями внутриклеточной концентрации Са++.
Форболовые эфиры активируют нейтрофилы, вызывают дегрануляцию, респираторный взрыв, увеличение содержания F – актина без увеличения внутриклеточной концентрации Са++.
Диоцилглицерин вызывает активацию специфического фермента клеток протеинкиназ С. Протеинкиназа С активируется на короткое время, но последствия её активации имеют длительный характер.
Подвижность нейтрофилов
Лейкоциты способны двигаться в тканях и через стенки сосудов, а также по поверхности чужеродного субстрата (стекло). При движении клетка изменяет форму.
рис. 2 Движение нейтрофила по субстрату.
Двигательный акт у ползающих клеток начинается с образования на переднем конце клетки отростка - ламеллоподии, далее в выступ, образованный прозрачной бесструктурной цитоплазмой, переливается жидкая зернистая цитоплазма тела лейкоцита. Формирование отростков представляет активный процесс, т.к. движущая сила и энергия заложены внутри самой клетки. Отростки в зависимости от среды имеют разную форму, они могут быть в виде узких длинны микровыростов, уплощенных ламеллоподий, а также в форме пузырей (Адо А.Д. Патофизиология фагоцитов 1961). Ламеллоподии образуются спонтанно на всех краях клетки, но способность передвигать клетку приобретает та ламеллоподия, которая вступила в контакт с субстратом (Stossel T.P. 1993).. Контакты могут быть как с поверхностью другой клетки, так и с не клеточной поверхностью. Ламеллоподии могут быть как разной формы, так и разных размеров. Конец отростка, коснувшись поверхности, может образовать прочный контакт. Нейтрофил во время движения образует широкую псевдоподию на переднем конце и узкие отростки на боковых поверхностях клетки.
С помощью интерференционной микроскопии различают 2 области контакта. Двигаясь, нейтрофил образует область плотного прилипания, это хвост и боковые отростки клетки, а область менее плотного прилипания образуется с телом клетки. Так как лейкоцит способен двигаться по неклеточной поверхности (стеклу), то можно наблюдать, как клетка теряет часть мембранного и цитоплазматического материала в виде следа на стекле. Это свидетельствует о плотном контакте с субстратом. Чтобы ослабить плотность контакта надо увеличить концентрацию сывороточного альбумина (King C. et. al 1980).
Натяжение отростка примыкающего к субстрату подтягивает клетку и образует новый участок для контакта с субстратом. Реакции прилипания повторяются многократно и составляют процесс распластывания клеток (Васильев Ю.М., Гельфанд И.М. 1977). Отросток, который только что начал образовываться не может прикрепиться к субстрату (стеклу) (King C.A., Preston T. M., Miller R.H. Donovan P. 1980).
Характеристики
Тип файла документ
Документы такого типа открываются такими программами, как Microsoft Office Word на компьютерах Windows, Apple Pages на компьютерах Mac, Open Office - бесплатная альтернатива на различных платформах, в том числе Linux. Наиболее простым и современным решением будут Google документы, так как открываются онлайн без скачивания прямо в браузере на любой платформе. Существуют российские качественные аналоги, например от Яндекса.
Будьте внимательны на мобильных устройствах, так как там используются упрощённый функционал даже в официальном приложении от Microsoft, поэтому для просмотра скачивайте PDF-версию. А если нужно редактировать файл, то используйте оригинальный файл.
Файлы такого типа обычно разбиты на страницы, а текст может быть форматированным (жирный, курсив, выбор шрифта, таблицы и т.п.), а также в него можно добавлять изображения. Формат идеально подходит для рефератов, докладов и РПЗ курсовых проектов, которые необходимо распечатать. Кстати перед печатью также сохраняйте файл в PDF, так как принтер может начудить со шрифтами.